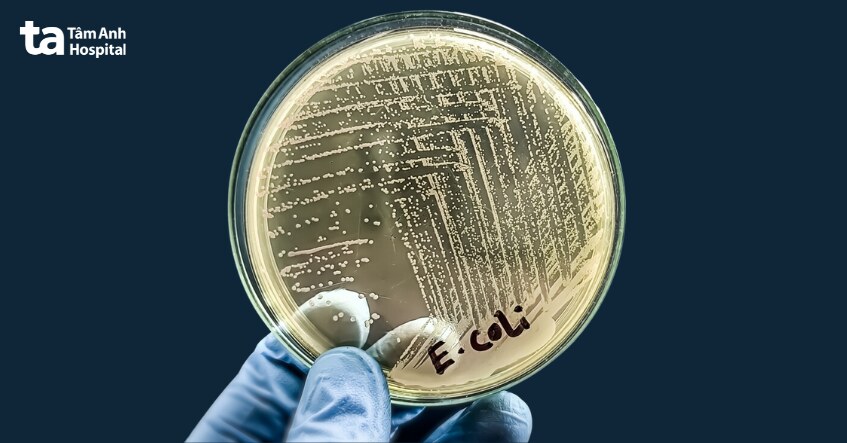
vi khuẩn e coli

Viêm tuyến tiền liệt có thể gây ảnh hưởng đến chất lượng tinh trùng, rối loạn cương dương,… Điều này khiến nhiều người khi nhận chẩn đoán mắc bệnh lo lắng, không biết “viêm tuyến tiền liệt có gây vô sinh không?” Thắc mắc này sẽ được bác sĩ CKI Phạm Cao Tháp, khoa Tiết niệu, Trung tâm Tiết niệu – Thận học – Nam khoa, BVĐK Tâm Anh TP.HCM giải đáp trong bài viết bên dưới.

Viêm tuyến tiền liệt có thể gây vô sinh, nhưng các trường hợp vô sinh do viêm tuyến tiền liệt rất hiếm. Ước tính có khoảng 12% trường hợp vô sinh là do nhiễm trùng đường sinh dục nam, bao gồm viêm tuyến tiền liệt, viêm mào tinh hoàn và viêm tinh hoàn. Viêm tuyến tiền liệt là 1 trong những vấn đề có liên quan đến vô sinh ở nam giới và việc điều trị viêm tuyến tiền liệt có thể phần nào giúp cải thiện chức năng sinh sản.
Tuyến tiền liệt là tuyến sinh dục phụ lớn nhất của nam giới, có vai trò quan trọng trong việc sản xuất 1 phần tinh dịch. Nó nằm ở đáy bàng quang và bao quanh phần gần niệu đạo. Tuyến tiền liệt gồm 2 loại mô chính: tế bào biểu mô và mô đệm. Tế bào biểu mô sản xuất các dịch tiết có chức năng hỗ trợ trong quá trình sinh tinh, trong khi mô đệm tạo thành các tế bào liên kết giúp duy trì cấu trúc của tuyến này.
Khi tuyến tiền liệt bị viêm, khối lượng dịch tiết của tuyến này có thể giảm, gây ảnh hưởng đến chức năng sinh lý của nó. Cụ thể, các chất như axit citric, alpha-glucosidase, fructose và kẽm là những yếu tố quan trọng trong việc duy trì hoạt động của enzyme và sự vận động của tinh trùng sẽ giảm xuống. (1)
Điều này có thể gây giảm chất lượng tinh dịch, tinh trùng từ đó ảnh hưởng tiêu cực đến khả năng sinh sản của nam giới. Viêm tuyến tiền liệt có thể xảy ra do nhiễm trùng hoặc viêm không do vi khuẩn và cần điều trị kịp thời để tránh những tác động lâu dài đến khả năng sinh sản.
Tác động của viêm tuyến tiền liệt lên các thông số tinh dịch vẫn còn gây tranh cãi. Nhiễm khuẩn đường sinh sản ở nam giới bao gồm viêm tuyến tiền liệt mạn tính do vi khuẩn đã được chứng minh là ảnh hưởng tiêu cực đến chất lượng tinh trùng. Trong nhiều nghiên cứu, viêm tuyến tiền liệt mạn tính không do vi khuẩn đã được chứng minh là có tác động tiêu cực đến hình thái và khả năng vận động của tinh trùng.
Viêm tuyến tiền liệt đặc trưng bởi tập hợp các triệu chứng và dấu hiệu thứ phát do nhiễm trùng và ảnh hưởng đến hầu hết nam giới trung niên với tỷ lệ mắc bệnh cao đáng kể. Người bệnh viêm tuyến tiền liệt thường cảm thấy khó chịu do diễn biến tự nhiên của bệnh. Chẩn đoán viêm tuyến tiền liệt chủ yếu bằng cách loại trừ các tình trạng khác và các lựa chọn điều trị bằng liệu pháp kháng sinh, sau đó tiến hành điều trị cải thiện khả năng sinh sản của nam giới và rối loạn chức năng tình dục tổng thể.

Viêm tuyến tiền liệt có con được. Mặc dù bệnh có thể ảnh hưởng đến khả năng sinh sản của nam giới, nhưng không đồng nghĩa với việc người bệnh không thể có con. Viêm tuyến tiền liệt có thể gây khó khăn trong việc thụ thai, tuy nhiên khả năng sinh con vẫn được duy trì nếu người bệnh được điều trị kịp thời.
Viêm tuyến tiền liệt có thể gây vô sinh tạm thời nếu không được chữa trị, do sự giảm sút chức năng của tuyến tiền liệt, làm giảm chất lượng tinh dịch, bao gồm giảm lượng dịch tiết và chất lượng tinh trùng. Tuy nhiên, với phương pháp điều trị thích hợp, đặc biệt là bằng kháng sinh, giúp giảm viêm và cải thiện chất lượng tinh dịch, người bệnh có thể phục hồi chức năng sinh sản và duy trì khả năng có con. Bên cạnh vấn đề viêm tuyến tiền liệt có gây vô sinh không thì nhiều người cũng tìm hiểu về nguyên nhân gây ra bệnh viêm tuyến tiền liệt.
Các nguyên nhân gây viêm tuyến tiền liệt gồm:
Các yếu tố nguy cơ của viêm tuyến tiền liệt gồm: tuổi (thường gặp ở nam giới trưởng thành hoặc trung niên), tiền sử viêm tuyến tiền liệt, nhiễm trùng hệ tiết niệu hoặc sinh sản, HIV/AIDS, sử dụng ống thông tiểu và các thủ thuật y tế liên quan đến tuyến tiền liệt.
Có thể bạn chưa biết: Viêm tuyến tiền liệt có quan hệ được không?
Viêm tuyến tiền liệt kéo dài có thể là dấu hiệu nguy hiểm. Nhưng không phải tất cả các trường hợp viêm tuyến tiền liệt kéo dài, hay viêm tuyến tiền liệt mạn tính đều là dấu hiệu của 1 tình trạng nguy hiểm. Nhìn chung, bệnh có thể ảnh hưởng nghiêm trọng đến chất lượng cuộc sống nếu không được điều trị đúng cách.
Viêm tuyến tiền liệt mạn tính thường kéo dài ít nhất 3 tháng và có thể gây ra các triệu chứng như đau ở vùng chậu, khó chịu khi đi tiểu, ảnh hưởng đến chức năng tình dục. Tình trạng này có thể xảy ra do các yếu tố như nhiễm trùng do vi khuẩn, tổn thương dây thần kinh hoặc những vấn đề khác, như rối loạn chức năng miễn dịch hoặc căng thẳng tâm lý.
Điều trị viêm tuyến tiền liệt mạn tính có thể bao gồm kháng sinh nếu có nhiễm trùng do vi khuẩn, nhưng kháng sinh không phải lúc nào cũng hiệu quả nếu không có bằng chứng rõ ràng về loại nhiễm khuẩn (4). Trong một số trường hợp, bác sĩ có thể chỉ định kết hợp kháng sinh với thuốc chẹn alpha để giảm đau và khó tiểu.
Viêm tuyến tiền liệt mạn tính có thể không đe dọa tính mạng, song nếu không được điều trị đúng cách, bệnh có thể gây ra các vấn đề lâu dài, như rối loạn chức năng tình dục và khó khăn trong việc đi tiểu. Do đó, nếu có triệu chứng viêm tuyến tiền liệt kéo dài, người bệnh nên tìm kiếm sự tư vấn và điều trị từ bác sĩ Tiết niệu để kiểm soát bệnh hiệu quả.

Khám và chữa viêm tuyến tiền liệt ở TPHCM tại khoa Tiết niệu, Trung tâm Tiết niệu – Thận học – Nam khoa, BVĐK Tâm Anh TP.HCM và Đơn vị Tiết niệu, Trung tâm khám chữa bệnh Tâm Anh Quận 7. Tại đây, quy tụ đội ngũ bác sĩ giỏi, là những chuyên gia giàu kinh nghiệm trong chẩn đoán và điều trị bệnh về hệ tiết niệu, trong đó có viêm tuyến tiền liệt.
Khi khám và chữa viêm tuyến tiền liệt tại Đơn vị Tiết niệu, Trung tâm khám chữa bệnh Tâm Anh Quận 7 hay khoa Tiết niệu, Trung tâm Tiết niệu – Thận học – Nam khoa, BVĐK Tâm Anh TP.HCM, người bệnh sẽ được các chuyên gia trực tiếp khám, áp dụng các thiết bị công nghệ cao trong chẩn đoán hình ảnh như MRI 3T – thiết bị chụp cắt lớp vi tính hiện đại nhất hiện nay để chẩn đoán chính xác, điều trị hiệu quả với phác đồ cá nhân hóa, bảo tồn chức năng sinh sản ở nam giới, hạn chế tối đa tình trạng viêm tuyến tiền liệt tiến triển thành mạn tính.
Như vậy, viêm tuyến tiền liệt có thể gây vô sinh nhưng rất hiếm. Người bệnh viêm tuyến tiền liệt được điều trị kịp thời bằng liệu pháp kháng sinh vẫn có thể có con. Chuyên gia, bác sĩ Tiết niệu khuyến cáo, nam giới bị viêm tuyến tiền liệt nên được điều trị càng sớm càng tốt, tránh các biến chứng nguy hiểm, ảnh hưởng đến chức năng sinh sản sau này.
HỆ THỐNG BỆNH VIỆN ĐA KHOA TÂM ANH
Hy vọng những thông tin bài viết vừa chia sẻ đã giúp bạn giải đáp được những bâng khuâng về việc viêm tuyến tiền liệt có gây vô sinh không? có con được không? Điều trị kịp thời đúng cách luôn là điều cần thiết để bảo vệ sức khỏe tuyến tiền liệt, chức năng sinh sản ở nam giới và chức năng tình dục về sau.